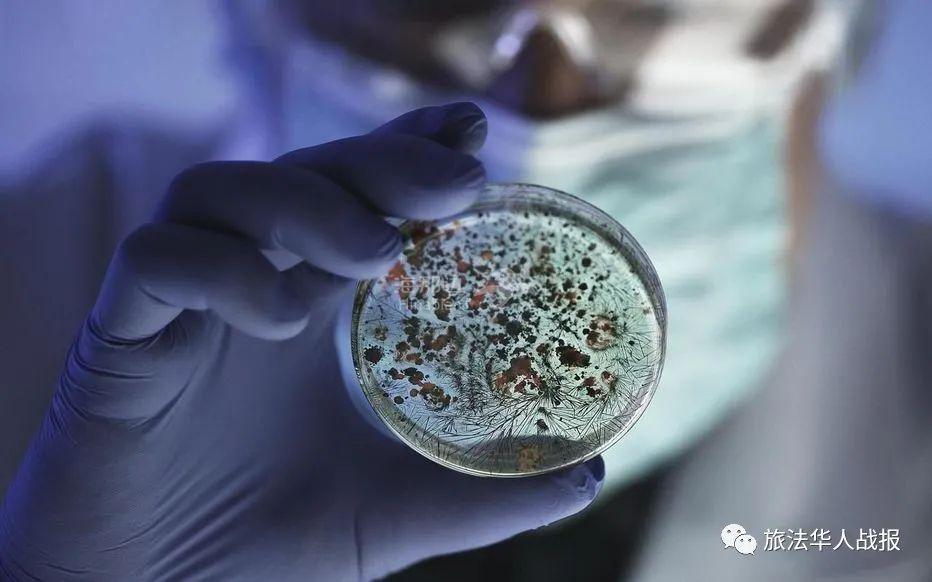
..

(点击图片,加入移民交流群)
巴黎2月16日电(鲁佳)截至16日下午,法国新冠肺炎确诊患者达3489129例,24小时内新增19590例;病亡患者共计82577例,增加351例。
(点击图片,加入移民交流群)
【法国疫情真的有所改善吗】
法国卫生部长奥利维耶韦兰(Olivier Véran)16日在国民议会上表示,希望2021年是战胜新冠疫情之年,希望法国人民和寰球人民能够重新获得所渴望的生活,重享日常生活的乐趣。
两周前,法国重启封锁的前景似乎不可避免,但令人担忧的疫情并未再次爆发,自1月底以来,疫情曲线停止了上升趋势。不过,尽管有积极迹象,大多数流行病学家对未来几周仍相当悲观。
法国流行病学家帕斯卡尔·克雷佩(Pascal Crépey)16日接受BFM电视台采访时表示,新毒株感染尚未爆发,但会加速传播,预计3月份英国新毒株感染将占主导地位。
法国流行病学家、蒙彼利埃大学流行病学讲师米尔切亚·索福内亚(Mircea Sofonea)认为,法国目前的措施可以控制新冠病毒原始毒株的传播,但基因测序表明,新毒株正在蔓延,当新毒株感染占据主导地位时,目前的措施可能已经不足以遏制疫情恶化。
全法范围内,病毒传播率(R指数)仍在1左右波动。米尔切亚·索福内亚解释说,英国发现的新毒株传染性比原始毒株高40%,现在原始毒株的传播率估计为0.9,而英国新毒株的传播率估计为1.3,新毒株感染者增加得越多,病毒传播率就会越高。
巴黎公共卫生研究所主任维多利亚·科利扎(Vittoria Colizza)预计,疫情形势在短期内将大致保持稳定。更重要的是,法国学校正处于寒假期间,按照不同地区,假期还将持续三周左右,因此很难预计假期的影响。万圣节假期使病毒传播得到一定程度的遏制,希望本次也能如此。但按照新毒株目前的传播速度,英国新毒株很可能在3月初占据主导地位,巴黎大区甚至会更早陷入这种局面,因此当前的限制程度可能不够。
法国诺尔省(Nord)敦刻尔克(Dunkerque)和摩泽尔省(Moselle)正在面临新毒株感染者激增的局势,其它省份也在担心爆发新疫情。15日,在发现160例南非和巴西新毒株感染患者后,多尔多涅省(Dordogne)六家养老院启动了大规模筛查,以打破病毒传播链。
米尔切亚·索福内亚警告说,在国外观察到的疫情演变在法国也可能重演,虽然环境不同,但结果类似。到目前为止,法国不能排除这样一种可能性,即一旦新毒株感染占据多数地位,英国所经历的情况也将在法国发生,然后病毒传播率将再次上升,住院患者数量随之激增,导致医院的重症服务陷入瓶颈,而接种疫苗的效果要到4月份才能显现。
维多利亚·科利扎认为,法国存在非常有限的回旋余地,可以设想现行措施至少维持到3月底而不重启封锁,但必须加强病例追踪并进行更严格的隔离。米尔切亚·索福内亚补充说,恢复正常生活的前景仍然很遥远。
【法国医护人员拒打阿斯利康疫苗】
(点击图片,加入移民交流群)
由于对英国牛津大学与阿斯利康制药集团联合开发的疫苗(Oxford/AstraZeneca)针对南非发现的新毒株效力较差,而且其可能产生的副作用令人存疑,法国卫生专业人员更愿意接种美国辉瑞(Pfizer)或莫德纳(Moderna)疫苗。
法国自2月6日起,将阿斯利康疫苗列为65岁以下卫生专业人员的优先选择。然而,法国医护人员宁愿等待,也不愿立即注射阿斯利康疫苗。医学界普遍关注该疫苗的两方面问题,一是目前还不确定阿斯利康疫苗对于南非和巴西发现的新毒株是否有效。尽管阿斯利康疫苗价格更低,保存更容易,但其效力只有约60%,对于某些病毒变种的效力可能降至50%、甚至不到25%。因此,南非政府已经停止阿斯利康疫苗的接种运动。在法国,新冠病毒新毒株的传播正在加速,人们不愿选择效力不确定的疫苗。
另一方面,法国国家药品安全管理局(ANSM)本月11日发出警示,称6日至10日上午,1万名注射了首剂阿斯利康疫苗的人员中有149份报告提到发生非常严重的不良反应,包括突发高烧、头痛、身体疼痛等,主要影响平均年龄为34岁的卫生专业人员。法国一些医院,尤其是布列塔尼大区(Bretagne)的医院,被迫调整其疫苗接种计划,以避免工作人员接种该疫苗后请病假从而造成医护人员短缺。在布列塔尼大区的布雷斯特(Brest),接种了该疫苗的医护人员有20%到25%因出现不良反应而停止工作。
摩泽尔省正在受到南非和巴西新毒株感染爆发的影响,该省卫生行业工人力量总工会代表莫尼克·弗朗索瓦(Monique François)介绍说,摩泽尔省日前又收到2000剂辉瑞和莫德纳疫苗,“许多人宁愿不接种疫苗,也不愿注射阿斯利康疫苗。”
法国传染病学家本杰明·达维多(Benjamin Davido)在接受《回声报》采访时指出,“用一种效力可能更差的疫苗为医护人员接种,这是不可接受的。病毒仍在广泛传播,如果明天医护人员都病倒了,没有人手为患者提供服务。”他补充说,他本人也不愿接种阿斯利康疫苗,宁愿继续等待。
巴黎内克尔医院(hôpital Necker)一名医生谈到,一些医护人员被通知可以接种阿斯利康疫苗,但由于缺乏愿意接种的人员,该计划在一日之内后就停止了。斯特拉斯堡(Strasbourg)一名医生表示,人们对这种疫苗存在很多疑问,但这很难量化。
法国青年医生工会主席伊曼纽尔·勒布(Emanuel Loeb)表示,希望卫生部能与卫生专业人员代表举行会议协商,或者让大家放心,或者提出另一种疫苗选择。法国自由医生联盟主席杰罗姆·马蒂(Jérôme Marty)15日通过BFM电视台呼吁,“不要将阿斯利康疫苗用于医护人员,而应为健康、低风险的年轻人接种。我们需要医护人员继续工作,这是利益与风险的平衡问题。”他还强调,阿斯利康疫苗“对南非新毒株无效”,而医护人员在工作中不可避免要接触南非新毒株感染者。
【千人音乐会要卷土重来了?】
(点击图片,加入移民交流群)
接下来的几个月,巴黎、马赛(Marseille)、圣马洛(Saint-Malo)和新阿基坦大区(Nouvelle Aquitaine)可能重新组织音乐会和音乐节,一批项目正在研究中。法国文化部长罗塞琳·巴舍洛(Roselyne Bachelot)15日证实,未来几周将举行几场试验性的音乐会。
西班牙和德国已经组织了这样的活动,英国和荷兰很快也会加入,但法国最近一年几乎没有举行过真正的音乐集会,本月12日,巴黎大区上塞纳省(Hauts-de-Seine)叫停了一场原计划1300人参与的音乐活动。
法国参议院文化事务委员会副主席凯瑟琳·杜马(Catherine Dumas)表示,政府在这一问题上非常谨慎,她1月14日提出的问题尚未得到书面答复,政府害怕一旦打开一个缺口,其他人都会纷纷提出要求。但她认为,疫情问题将在很长一段时间内持续存在,因此必须采取适当措施,重新开始文化活动。
法国传染病学专家皮埃尔·塔文(Pierre Tattevin)认为,法国政府从一开始就对文化行业非常严格,“客观地说,当购物中心重新营业时,我无法理解对文化机构的这种不妥协态度。剧院、电影院和博物馆本可以小心翼翼地保持开门。不过,这种情况似乎正在改变,当局的态度已经更加开放。”根据法国文化部的说法,对于巴黎和马赛提出的音乐活动计划很感兴趣,但这最终将取决于卫生部。
法国音乐娱乐联盟(Prodiss)正在与巴黎大区公立医院集团(AP-HP)及法国国家健康与医学研究院(Inserm)共同研究在巴黎贝尔西体育馆(Accor Arena de Paris)举办3000人到5000人表演活动的计划,观众佩戴口罩但无需保持人际距离。法国音乐娱乐联盟成员、巴黎“我们爱绿色”电影节(We Love Green)主任玛丽·萨伯特(Marie Sabot)补充道,会要求每名观众持有72小时内的PCR检测阴性证明,就像乘坐飞机一样。民意调查显示,92%的人愿意为此接受病毒检测,大部分是25岁至35岁的年轻人。
马赛也正在计划两场音乐会,时间在3月至4月,观众都达到上千人,但观众要在音乐会前24小时至48小时接受病毒检测,并在7天和14天后再次接受检测。今年5月,圣马洛附近的圣父堡(Fort de Saint-Père)计划举办“无标志节”音乐会(Le festival No Logo BZH),两晚安排2000人入内。新阿基坦大区正在对举办有关活动进行风险测试。
【奥利机场只剩一个航站楼继续运作】
(点击图片,加入移民交流群)
巴黎奥利机场(aéroport d’Orly)从16日起关闭4号航站楼。该机场的1号航站楼及2号航站楼已关闭数月,因此现在只有更现代化、更适合国内和国际航班的3号航站楼继续运作,为乘客提供服务。
新冠疫情导致的旅行限制,使得寰球各地空中交通流量都严重下降。2020年4月1日起,巴黎奥利机场曾完全关闭,直至6月26日才重新开放,但部分航站楼于11月再次关闭。本月起,法国政府禁止一切与欧洲外部国家和地区的非必要旅行,只有出于家庭、职业、教育、健康方面的紧急原因才可豁免,这使得国际空中交通再遭沉重打击,过去几天,奥利机场的乘客和航班数量都大幅下降。例如,摩洛哥皇家航空公司(Royal Air Maroc)在该机场运营的航班从每日12趟减少到2趟,阿尔及利亚航空公司(Air Algérie)的每日两趟航班已被转移到巴黎戴高乐机场。
2月11日,巴黎戴高乐机场的4号航站楼项目被放弃,这也表明,航空业仍面临不确定的前景。
而这些举措对于员工影响巨大,包括分包商甚至边境警察都会受到波及,大批工作人员要被纳入“非全时失业”计划。2020年4月巴黎奥利机场完全关闭时,2.5万名员工被迫停工。2020年,奥利机场只接待了1080万乘客,比2019年下降66.1%。
【“非全时失业”现行政策延长一个月】
(点击图片,加入移民交流群)
法国劳工部长伊丽莎白·博恩(Élisabeth Borne)16日宣布,目前的“非全时失业”条件将在3月份继续维持不变,该计划的支付比例原定于2月底进行调整。
伊丽莎白·博恩表示,当局决定在3月份延续目前的“非全时失业”补偿比例。也就是说,“非全时失业”员工可获得税前工资的70%,税后工资的84%。受疫情影响严重的行业,国家仍将承担“非全时失业”员工百分百的薪资,对于其它行业,企业负担的部分仍为15%。
政府原计划在3月份对于补偿比例作出调整,旅游、文化、体育、休闲、酒店、餐饮、交通、活动等受疫情影响严重的行业继续受益于百分百援助,但其它行业,雇主承担的比例将升至40%。
伊丽莎白·博恩强调,鉴于疫情形势的不确定性,为了继续保护就业,这种延长是合理的,尽管国家已为此斥资近30亿欧元。2020年春季首要次封锁期间,受益员工为900万,11月第二次封锁期间受益员工为300万。
伊丽莎白·博恩呼吁企业首先要保护就业岗位,此外要利用员工停止或减少工作的机会加强培训,让员工在此期间学习或发展新技能,以便使企业在疫情危机结束后变得更强大。她还提到了另一项计划,允许对就业受到威胁的员工进行长达18个月的培训,以便在其他行业重新就业,例如“让收银员或保洁员参加护理助理培训”,国家将承担百分百的培训费。
【搬家津贴受益范围扩大】
(点击图片,加入移民交流群)
法国住房部长艾曼妞·瓦贡(Emmanuelle Wargon)15日宣布,18日起,将两年前开始实施的搬家津贴受益范围扩大到25岁以下年轻人。
据《费加罗报》报道,受益年轻人无论签署长期合同(CDI)、短期合同(CDD)或临时合同(intérim),都可以获得这笔1000欧元的援助。但受益人必须符合四个条件:25岁以下;税前工资不超过较低工资(smic)的1.1倍,亦即月薪1300至1400欧元;租房居住并拥有租房合约;进入职场不满18个月。
另一方面,对于签署交替培训合同的年轻人没有受益年龄限制。按照住房部长的说法,在此时期,支持最困难群体至关重要,年轻人当前处境艰难,当他们能够安定下来,拥有一份工作,就可以有一个良好的生活开端。
法国益普索调查公司(Ipsos)最近为皮埃尔神父基金会进行的一项民调显示,超过35%的年轻人担心在2021年将难以支付房租。另据该协会的数据,疫情封锁期间,36%的在职学生停止打工,其中只有27%的学生受益于“非全时失业”(chômage partiel)计划。
【图说】
(点击图片,加入移民交流群)
法国2020年第三季度的失业率为9.1%,第四季度下降至8%,但法国国家统计与经济研究所(Insee)认为,这是一种误导性的下降,一些人在第二次封锁期间已经放弃找工作。
(点击图片,加入移民交流群)
欧盟委员会主席乌尔苏拉·冯德莱恩(Ursula von der Leyen)在接受法国《回声报》采访时宣布,一项研究新冠病毒变种的欧洲计划即将启动,该计划将汇集实验室、卫生当局、医学专家,并投入大量资金。她还呼吁制药实验室携手开发改良疫苗。
(点击图片,加入移民交流群)
美国强生公司(Johnson & Johnson)向欧盟递交疫苗申请。强生疫苗的效力约为66%,但对南非新毒株的效果较差。该疫苗的优点是只需注射一剂,而且可以在2至8度的环境下储存。
(点击图片,加入移民交流群)
德国捷孚凯市场研究公司(GfK)进行的新近调查显示,2020年法国及外国家用电器市场营业额为91亿欧元,增长了5%。其中,冰箱的销售额增长18%,面包机销售额增长82%,酸奶、糕点机销售额增长47%,咖啡机销售额增长11%。
(点击图片,加入移民交流群)
法国负责旅游事务的国务秘书让-巴蒂斯特·勒莫尼(Jean-Baptiste Lemoyne)16日表示,关于“疫苗护照”的辩论在欧洲存在分歧,法国的观点是“这为时过早”,法国目前只有少数人接种了疫苗,如果持有疫苗护照才能旅行,这涉及道德问题。法国截至16日共进行了316.2万次疫苗注射,其中2347088人注射了首要剂,占总人口的3.5%和成年人口的4.4%,815547人完成两剂疫苗接种。
(点击图片,加入移民交流群)
上法兰西大区(Hauts-de-France)卫生机构宣布,18日和19日将在敦刻尔克(Dunkerque)、卡佩勒布鲁克(Cappelle-Brouck)、贝尔格(Bergues)和沃尔穆(Wormhout)展开一项特别筛查,在当地生活和工作的人员可无需预约并且无需处方地参加免费检测。此外,还将额外拨付2400剂疫苗,以应对日益恶化的疫情状况。
(点击图片,加入移民交流群)
敦刻尔克市长帕特里斯·维格里特(Patrice Vergriete)16日介绍说,当地现在的发病率(每周每10万居民中的确诊数)为658例,而2月7日的一周为515例,更前一周为384例。他还表示,该市四分之一的家长没有让孩子上学。
(点击图片,加入移民交流群)
巴黎大区和里昂(Lyon)正在测试一种特殊布料,据称能够杀灭99.9%的病毒、微生物和细菌,包括新冠病毒。这种布料已经安装在里昂地铁C线的一些列车以及巴黎地区的几辆公交车上。这项由Trajet-Aunde公司开发的技术有效性得到了一家独立实验室的证实,测试结果预计将在5月份公布。
(点击图片,加入移民交流群)
巴黎大区附近城市博韦(Beauvais)市长卡洛琳·卡耶(Caroline Cayeux)向文化部提议,在博韦试行重新开放博物馆等文化机构。
(点击图片,加入移民交流群)
游轮行业急于重启运营,但分析认为,最早也要到2021年的下半年,该行业才能恢复正常。随着全球疫苗接种运动的开展,业内已经看到复苏的迹象。
【国际】
(点击图片,加入移民交流群)
新冠病毒疫情在全球造成确诊患者超过1.09亿例,病亡患者超过240.8万例。受疫情影响最严重的美国确诊患者超过2769.4万例,病亡患者超过48.6万例。其次是巴西确诊患者超过986.6万例,病亡患者超过23.9万例;墨西哥确诊患者超过199.5万例,病亡患者超过17.4万例;印度确诊患者超过1092.5万例,病亡患者超过15.5万例;英国确诊患者超过404.7万例,病亡患者超过11.7万例。
荷兰海牙(La Haye)一家法院16日裁定,荷兰政府必须立即解除目前的宵禁。荷兰政府于2月初宣布,全国范围内从晚21点至早晨4点30分实施宵禁,直至3月2日。面对法院的裁决,荷兰首相马克·吕特(Mark Rutte)表示将提起上诉,同时呼吁荷兰人“继续遵守宵禁规定”。
德国西北部的奥斯纳布吕克(Osnabrück)一家冰淇淋厂爆发集群感染,200多人被确诊,850名员工被隔离,该工厂已经关闭。
德国将与奥地利蒂罗尔州(Tyrol)以及捷克的边境管制延长到3月初,以防新毒株传播。这些严格的交通限制也适用于南非、英国和巴西等发现了新毒株的国家。
苏格兰将于下周开始逐步重新开放学校,一些小学生和初中生将首批复课,其他学生将从3月中旬开始跟进。
摩洛哥政府将2020年12月底以来实行的21点至早晨6点的宵禁措施延长到3月2日,商店和餐馆须在20点之前关闭。
以色列继续放宽限制措施,政府上周宣布允许某些商店和服务开放后,又决定从21日起允许街头商贩、购物中心、市场、博物馆、书店重新营业。但体育馆、酒店、游泳池和娱乐场只能接待完成两剂疫苗注射或感染新冠痊愈人员。根据该国总理府的说法,如果感染人数继续下降,餐馆和酒吧将从3月7日恢复营业。
哈萨克斯坦卫生部15日向Karaganda制药公司颁发了生产俄罗斯Spoutnik V疫苗的授权,由此成为首先批准在当地生产该疫苗的国家。
多米尼加共和国宣布于16日启动新冠疫苗接种运动。
智利开始为教师接种疫苗,目标是在3月1日学年开始前重新开放学校。
巴西开展疫苗接种运动已有一个月,2.12亿人口中超过2%接种了疫苗。但在国家政府没有明确指示的情况下,各州和城市放任自流,出现了欺诈等多种状况,甚至里约热内卢(Rio de Janeiro)等地由于剂量不足而暂停接种。
南非推迟了阿斯利康疫苗的接种计划,因为这种疫苗被质疑效力不足。南非卫生部表示,愿向非洲联盟转让100万剂,给那些有兴趣购买的国家。
哥伦比亚收到了首批50万剂美国辉瑞(Pfizer)与德国BioNTech生物技术公司联合疫苗,将于20日启动接种运动。
日本政府14日批准了美国辉瑞(Pfizer)与德国BioNTech生物技术公司联合疫苗,接种运动将于17日启动,但只有小部分卫生人员参与接种,老年人最早要等到4月份。